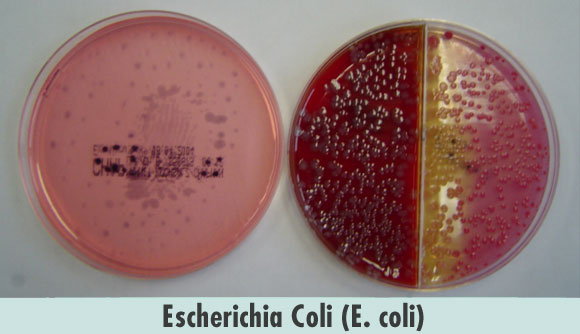

Arbeitskreis Tiergesundheit: Gemeinsam erfolgreich sein, gemeinsam Zukunft haben!
Die Milchpreise steigen endlich wieder an, das ist eine sehr erfreuliche Entwicklung, die auch vonnöten ist. Was können wir aus der Milchkrise lernen? Jeder muss seine Kosten noch mehr unter die Lupe nehmen. Dazu gehören natürlich auch die viel diskutierten Tierarztkosten. Diese können wir nur senken, indem wir uns noch mehr um die Tiergesundheit unserer …